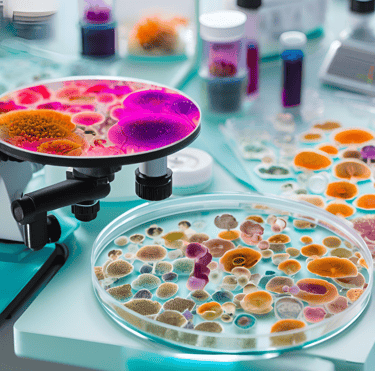
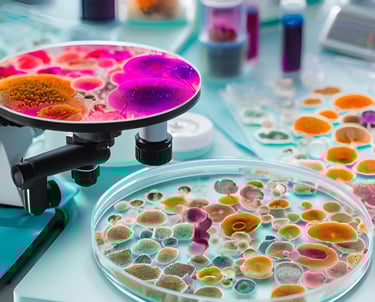

Estudios Científicos
Compromiso inquebrantable con la investigación
En esta sección, encontrarás una selección de estudios realizados por el destacado investigador Garífuna, Dr. Wilker Gotay.
Sus contribuciones científicas, publicadas en prestigiosas revistas internacionales, reflejan un compromiso inquebrantable con la investigación, el progreso humano y el desarrollo de la comunidad. Descubre cómo su trabajo impulsa el conocimiento y fortalece los pilares de GGI.


Este estudio revela cómo ciertas variantes genéticas en los genes TLR7 y TLR8, ubicados en el cromosoma X, están asociadas con una mayor protección frente a la fiebre Chikungunya. Una investigación que abre puertas hacia la medicina personalizada y estrategias de prevención más efectivas.
👉 Leer estudio completo
🧬 GenX Defender: Mutaciones que Blindan contra el Chikungunya


Este estudio analiza cómo los polimorfismos genéticos en el sistema inmune influyen en la respuesta del organismo al virus del Chikungunya. La revisión destaca factores genéticos clave en la evolución de esta enfermedad, ofreciendo nuevas perspectivas para el diagnóstico y tratamiento.
Leer el estudio completo
La Genética del Sistema Inmune y su Impacto en el Chikungunya

Publicado en Medical Mycology, este artículo profundiza en las infecciones fúngicas emergentes, su diagnóstico y tratamiento. Es una referencia clave para comprender el impacto de los hongos en la salud global.
Leer el estudio completo
Hongos y Salud: Nuevas Perspectivas en Micología Médica


Este trabajo aborda la resistencia bacteriana a los antibióticos, explorando las implicaciones clínicas y nuevas estrategias para combatirla. Una investigación fundamental para enfrentar esta creciente amenaza.
Leer el estudio completo
La Resistencia Bacteriana: Un Desafío Moderno en Microbiología Clínica


Este estudio del repositorio de la Universidad Federal de Ceará examina nuevas técnicas moleculares para el diagnóstico de enfermedades tropicales, contribuyendo al control de epidemias en regiones vulnerables.
Leer el estudio completo
Avances en el Diagnóstico Molecular de Enfermedades Tropicales


En este trabajo, se investigan patógenos emergentes y su impacto en la salud pública global. Ofrece datos relevantes para prevenir y manejar futuras pandemias.
Leer el estudio completo
